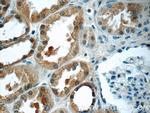
SCRN3 Antibody in Immunohistochemistry (Paraffin) (IHC (P))

Search
Proteintech
SCRN3 Polyclonal Antibody
{{$productOrderCtrl.translations['antibody.pdp.commerceCard.promotion.promotions']}}
{{$productOrderCtrl.translations['antibody.pdp.commerceCard.promotion.viewpromo']}}
{{$productOrderCtrl.translations['antibody.pdp.commerceCard.promotion.promocode']}}: {{promo.promoCode}} {{promo.promoTitle}} {{promo.promoDescription}}. {{$productOrderCtrl.translations['antibody.pdp.commerceCard.promotion.learnmore']}}
产品信息
13240-1-AP
种属反应
宿主/亚型
分类
类型
抗原
偶联物
形式
浓度
规格
纯化类型
保存液
内含物
保存条件
运输条件
产品详细信息
Immunogen sequence: MVFSYHNSF LIADRNEAWI LETAGKYWAA EKVQEGVRNI SNQLSITTKI AREHPDMRNY AKRKGWWDGK KEFDFAAAYS YLDTAKMMTS SGRYCEGYKL LNKHKGNITF ETMMEILRDK PSGINMEGEF LTTASMVSIL PQDSSLPCIH FFTGTPDPER SVFKPFIFVP HISQLLDTSS PTFELEDLVK KKSHFKPDRR HPLYQKHQQA LEVVNNNEEK AKIMLDNMRK LEKELFREME SILQNKHLDV EKIVNLFPQC TKDEIQIYQS NLSVKVSS (1-277 aa encoded by BC031821)
靶标信息
SCRN3 is a member of the secernin family of proteins which includes the homologous SCRN1, a protein that was first identified as being involved in the regulation of exocytosis from peritoneal mast cells. Little is known of SCRN3, but studies have shown that SCRN1 may possess epitopes that function as tumor-associated antigens in gastric cancers and increased SCRN1 expression in patients with colorectal cancer correlated with poor prognosis, suggesting that SCRN3 may also be involved in protein secretion or the regulation of cell growth.
仅用于科研。不用于诊断过程。未经明确授权不得转售。
篇参考文献 (0)
生物信息学
蛋白别名: Secernin-3; unnamed protein product
基因别名: 4833415E20Rik; AI427019; AV002033; SCRN3; SES3
UniProt ID: (Human) Q0VDG4, (Mouse) Q3TMH2
Entrez Gene ID: (Human) 79634, (Mouse) 74616, (Rat) 311731